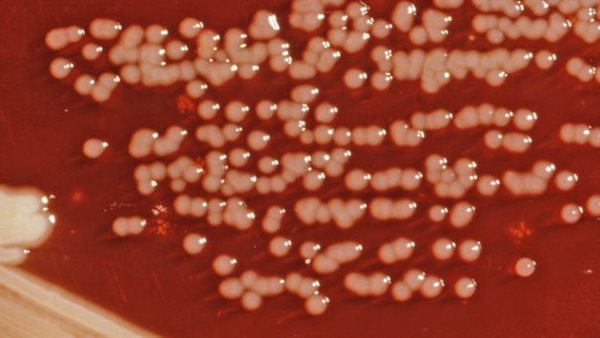
طفيل يرسينيا إنتينكوليتيكا

تفشي عدوى طفيلية تنتقل عن طريق الغذاء ببعض الدول الأوروبية
حذر خبراء الصحة، من عدوى طفيلية خطيرة تنتقل عن طريق الغذاء، وتسبب الإسهال الدموي، إذ أصيب 133 شخصا بالمرض، وظهرت حالات الإصابة في أربع نقاط ساخنة للعطلات الصيفية.
تفشي عدوى طفيلية ببعض الدول الأوربية
وحذر المركز الأوروبي للوقاية من الأمراض ومكافحتها، من تفشي طفيل يرسينيا إنتينكوليتيكا التي أثرت على 136 شخصا في أربعة بلدان مختلفة، وجرى ربط تفشي المرض بتناول الجبن، وتميل البكتيريا إلى أن تنتقل من خلال تناول الطعام الملوث، وخاصة لحم الخنزير النيئ أو غير المطبوخ جيدًا، وتسبب مرضا يسمى داء اليرسينيات.
ووفقًا لما نشر في صحيفة ذا صن البريطانية، يمكن أن ينتقل أيضا من خلال الاتصال بشخص كان يتعامل مع منتجات لحم الخنزير، أو شرب الحليب الملوث أو المياه غير المعالجة، أو الاتصال بالحيوانات.
وحدد المركز الأوروبي للوقاية من الأمراض ومكافحتها، جبن الماعز بالحليب الخام المنتج في فرنسا كوسيلة للعدوى، إذ أن بين يناير و11 يوليو من هذا العام، جرى الإبلاغ عن 133 حالة من داء اليرسينيات في فرنسا، ولوحظ استهلاك مرتفع بشكل غير عادي لجبن الماعز بالحليب الخام.
وشهدت منطقة بروفانس ألب كوتد أزور في جنوب شرق فرنسا، أكبر عدد من الحالات، إذ مرض 57 شخصا، وتراوحت أعمار المتضررين بين ثلاث سنوات و85 عاما، وكان 57 في المائة منهم من النساء، ولكن تم تحديد الحالات في جميع مناطق البر الرئيسي لفرنسا، وأشار المركز الأوروبي إلى أنه تم تحديد الحالات.
وقال مركز السيطرة على الأمراض والوقاية منها، إن أعراض عدوى يرسينيا غالبا ما تعتمد على عمر المصابين، ويميل الأطفال الصغار إلى الإصابة بالحمى وآلام المعدة والإسهال الذي يمكن أن يكون دمويًا، ويعاني الأطفال الأكبر سنا والبالغين من ألم على الجانب الأيمن من بطنهم، ويمكن الخلط بينه وبين التهاب الزائدة الدودية، وكذلك الحمى.
وأفادت السلطات الصحية في بلجيكا، أن رجلا أصيب بعدوى يرسينيا إنتينكوليتيكا في أبريل، كما مرضت امرأة في لوكسمبورغ في أبريل وأصيبت امرأة أخرى بالعدوى المنقولة بالغذاء في مارس في النرويج.
تاريخ تفشي المرض
وجرى الإبلاغ عن تفشي المرض في تقرير تهديدات الأمراض المعدية الذي نشرته ECDC في 12 يوليو، وفي أحدث تقرير لها تبين إن تفشي المرض كان تحت الرصد النشط، وبالنظر إلى توزيع المنتجات المتورطة في العديد من بلدان الاتحاد الأوروبي، وجد خبراء الصحة إن خطر الإصابة بمرض اليرسين مرتفع بين المستهلكين الذين اشتروا المنتجات تتضمن الطفيل المعدي.
طرق انتقال العدوى
وبحسب خبراء الصحة، يرسينيا هي بكتيريا يمكن أن تجعل الناس مرضى وتسبب الإسهال، ويشمل النوعان من الجراثيم يرسينيا إنتيروكوليتيكا، ومرض السل الكائف يرسينيا، ويسمى المرض الذي يمكن أن تسببه هذه الأنواع من يرسينيا داء اليرسينيات، والذي يمكن أن يصيب الأشخاص الذين يتناولون البكتيريا من خلال الطعام الملوث أو يتلامسون مع شخص يتعامل مع المنتجات مع البكتيريا، وتشمل الأسباب الشائعة للعدوى ما يلي:
- الطعام الملوث، وخاصة لحم الخنزير النيئ أو غير المطبوخ جيدا
- تواصل مع شخص أعد منتج لحم الخنزير
- شرب الحليب الملوث أو المياه غير المعالجة
- الاتصال بالحيوانات أو بيئاتها أو برازها
- الاتصال بشخص آخر طريق عدم غسل اليدين جيدًا.






















